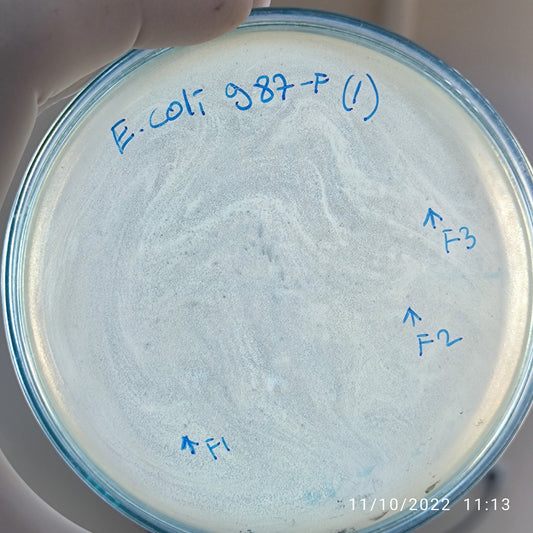
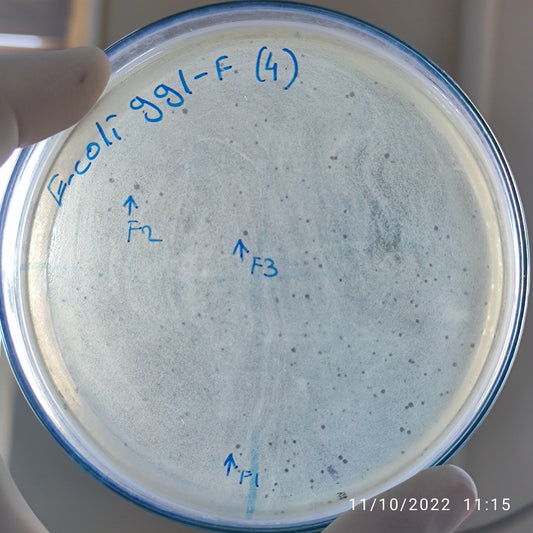
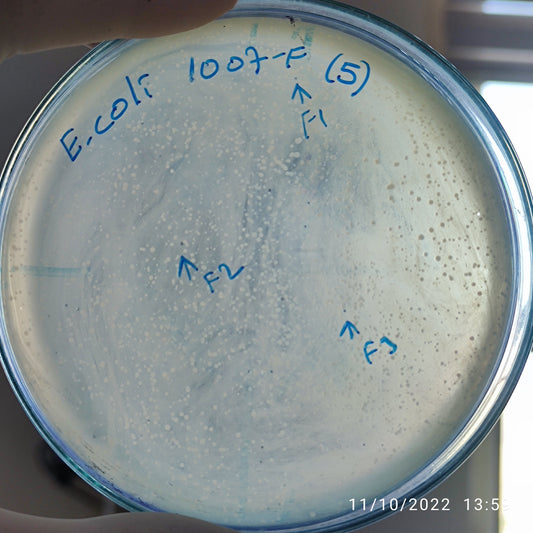

-
Escherichia coli bacteriophage 100986G
Regular price $500.00 USDRegular priceUnit price per -
Escherichia coli bacteriophage 100987F
Regular price $500.00 USDRegular priceUnit price per -
Escherichia coli bacteriophage 100990F
Regular price $500.00 USDRegular priceUnit price per -
Escherichia coli bacteriophage 100991F
Regular price $650.00 USDRegular priceUnit price per -
Escherichia coli bacteriophage 100995F
Regular price $500.00 USDRegular priceUnit price per -
Escherichia coli bacteriophage 100998F
Regular price $650.00 USDRegular priceUnit price per -
Escherichia coli bacteriophage 101000F
Regular price $500.00 USDRegular priceUnit price per -
Escherichia coli bacteriophage 101000G
Regular price $500.00 USDRegular priceUnit price per -
Escherichia coli bacteriophage 101001F
Regular price $500.00 USDRegular priceUnit price per -
Escherichia coli bacteriophage 101002F
Regular price $600.00 USDRegular priceUnit price per -
Escherichia coli bacteriophage 101005F
Regular price $500.00 USDRegular priceUnit price per -
Escherichia coli bacteriophage 101005G
Regular price $500.00 USDRegular priceUnit price per -
Escherichia coli bacteriophage 101007F
Regular price $500.00 USDRegular priceUnit price per -
Escherichia coli bacteriophage 101008F
Regular price $650.00 USDRegular priceUnit price per -
Escherichia coli bacteriophage 101008G
Regular price $900.00 USDRegular priceUnit price per -
Escherichia coli bacteriophage 101011F
Regular price $500.00 USDRegular priceUnit price per